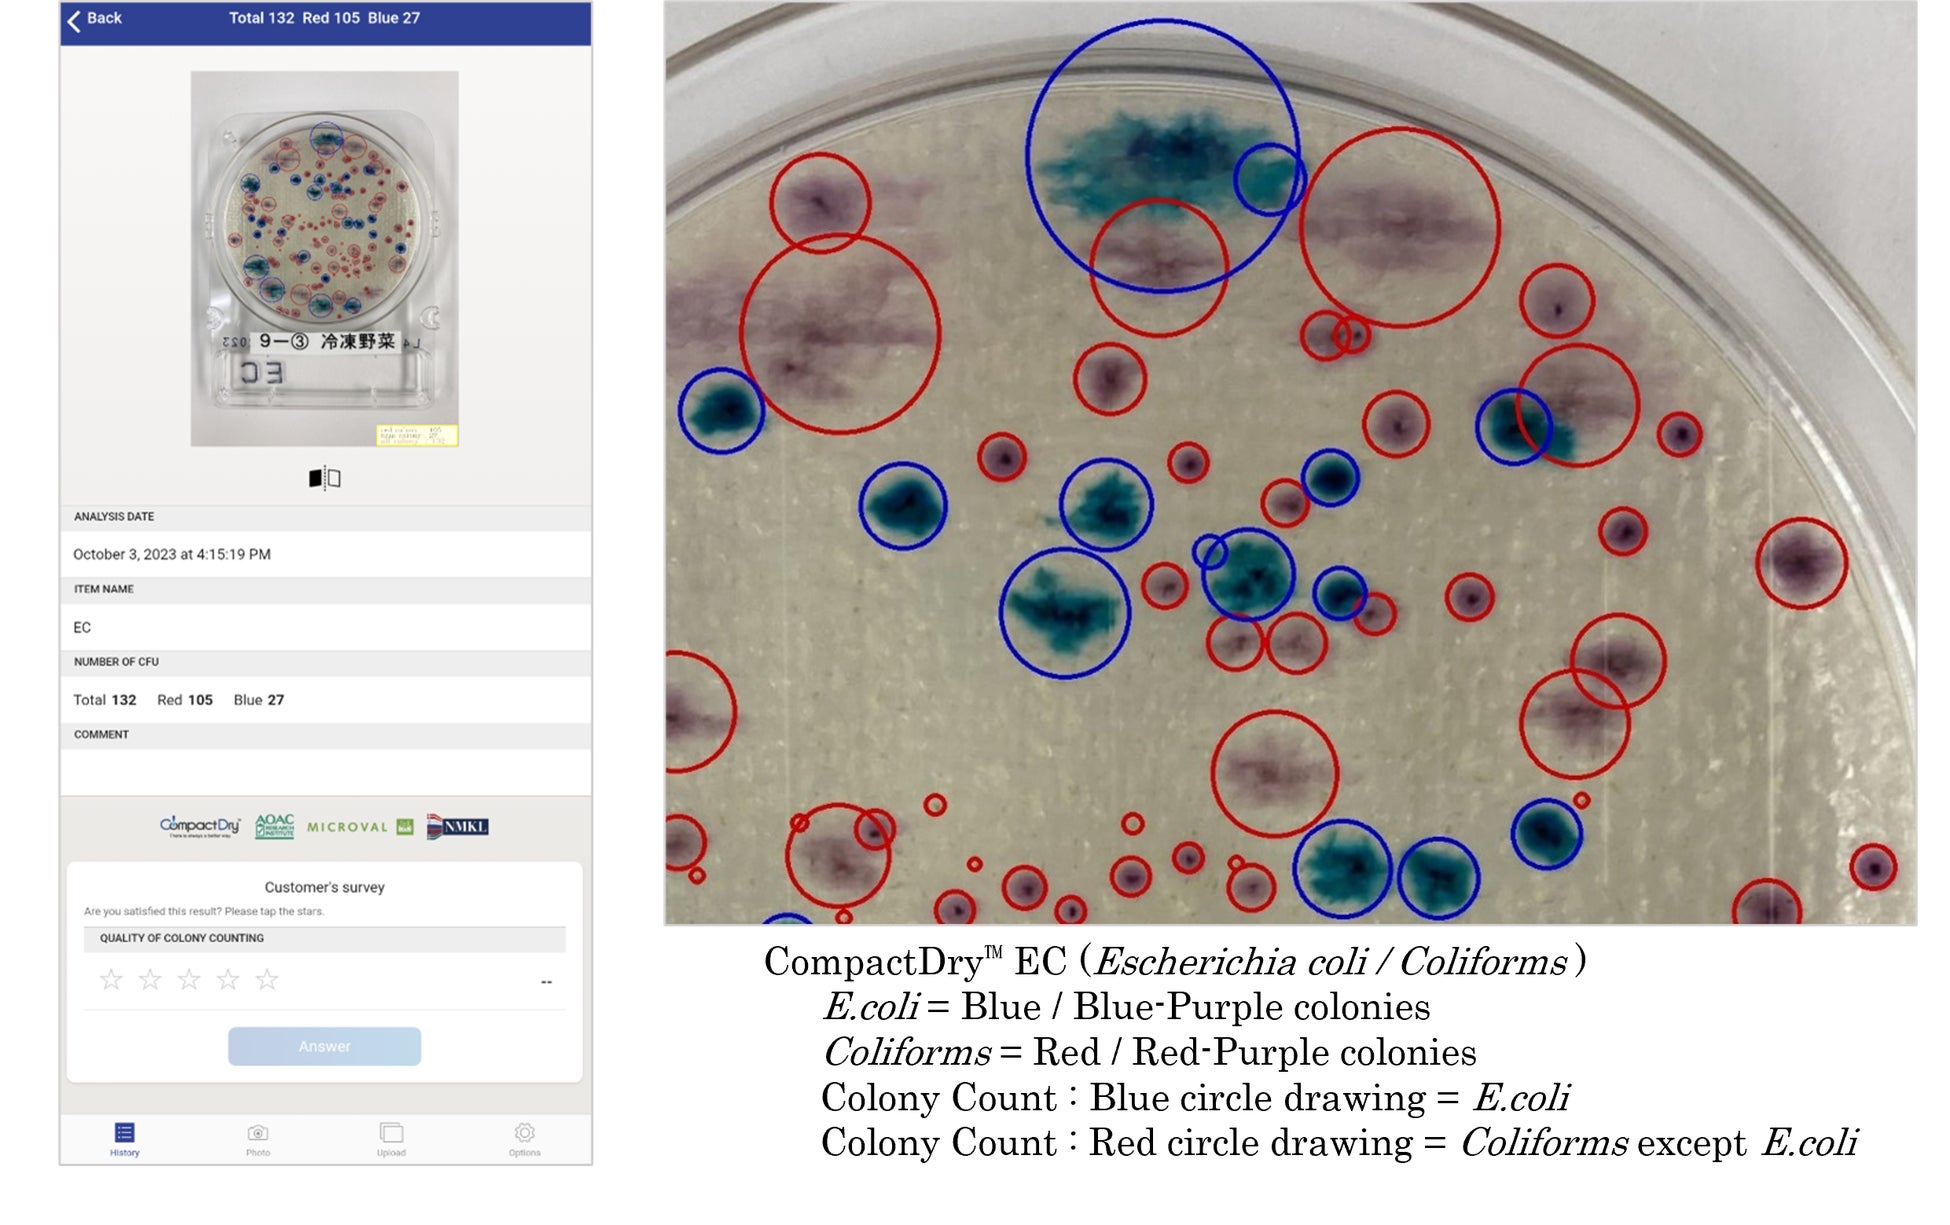
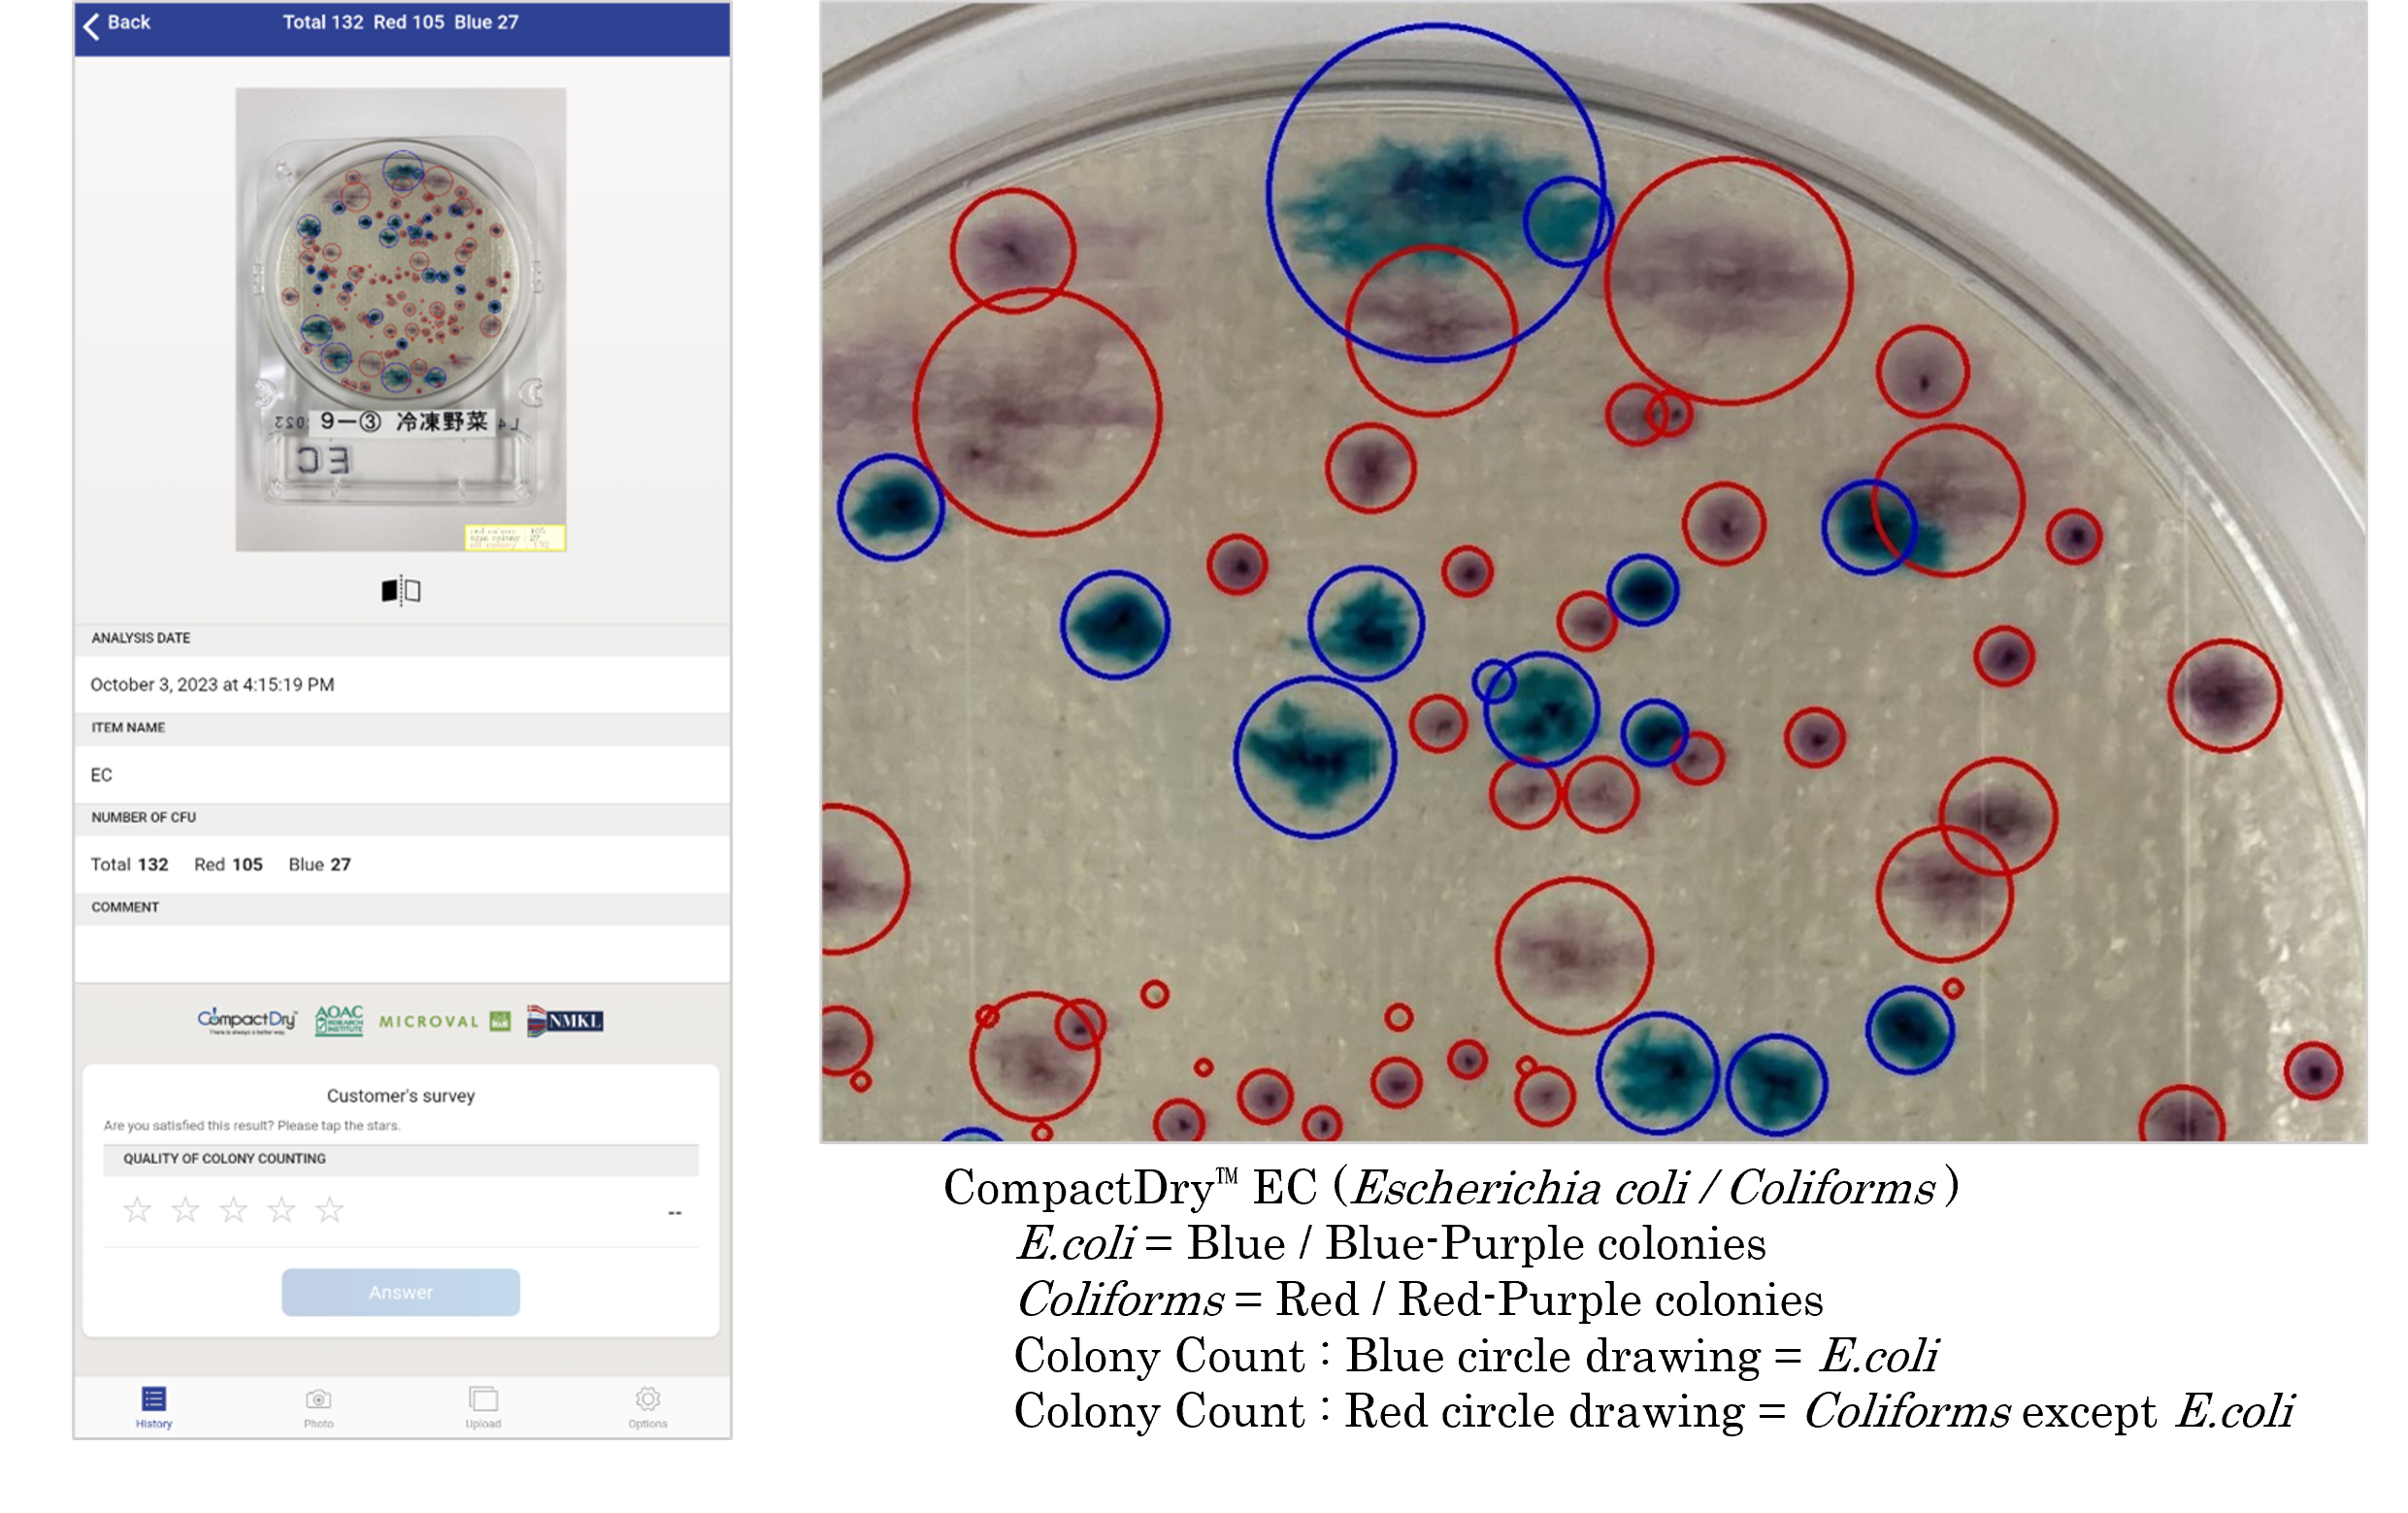

コロニーカウンターグローバルサービス「@BactLAB™」新規AI(人工知能技術)ソリューションに関するお知らせ
ご関係者 各位
2023年10月13日
島津ダイアグノスティクス株式会社
コロニーカウンターグローバルサービス「@BactLAB™」
新規AI(人工知能技術)ソリューションに関するお知らせ
弊社は、海外における食品衛生に関する市場開拓と品質管理への貢献を目的として、2018年8月よりAWS(Amazon Web Service)クラウドとAI(人工知能技術)を利用して迅速・簡単にコロニーのカウントができるアプリケーション「@BactLAB™」(以下、@BactLAB)を、海外市場における弊社主力製品である菌数測定用簡易培地CompactDry™ の利用企業に向けたソリューション展開をしておりますが、この度、@BactLABに新しいAI(人工知能技術)・機能改良を実装しましたのでお知らせいたします。

デバイスプラットフォーム: Google Play / Apple Store / amazon appstore / PC (Online Service)
@BactLAB公式サイト : https://corp.sdc.shimadzu.co.jp/english/products/global/bactlab/

【@BactLAB 対応デバイスプラットフォームについて】
Google Play : Android 13.0 or later
Apple Store : iOS 16.3 or later.
amazon appstore : Android 13.0 or later / Fire OS 8.3.1.2 or later
PC (Online Service) : Windows 11 or later (Edge, Firefox, Chrome)
MacOS 13.2 or later and a Mac with Apple M1 chip or later (Safari, Firefox, Chrome)
【アプリケーションダウンロード】
https://corp.sdc.shimadzu.co.jp/english/products/global/bactlab/application.html
【@BactLAB 新しいAI(人工知能技術)の概要について】
コロニーのカウント処理について、2018年8月リリースした初期搭載AIモデルでの処理は、コロニーの位置検出の為に「画像処理」と「機械学習(Deep Learning)」を併用したカウント技術画像処理を実装していましたが、2023年10月にリリースしたAIモデルでは、位置(領域)検出とクラス分類までを1つのネットワークで処理する物体検知AIネットワーク(機械学習モデル)【YOLOv4】をバックボーンとしコロニーの検知(カウント)に特化した推論検証の試験を重ね、ビジネス用途に考慮したハードチューニングAIとして実装しています。
リアルタイムオブジェクト検出アルゴリズムと呼ばれる物体検知AIネットワーク【YOLOv4】は、「You Only Look Once」の頭文字に由来しており、その特性である“シングルショットでの物体検出の特性”“リアルタイム検出に強いアルゴリズム”“処理速度が非常に利点”を活かすことで、パフォーマンスの最大化を実現しコロニーカウントの精度と処理速度に貢献しています。ぜひご利用して頂き、体感してみてください。
【@BactLAB サービスの表現および仕様に関するご注意について】
* 提供機能などに関しては、順次新サービスを提供しており、掲載説明と若干異なる場合が
ありますのでご了承ください。
* 本サービスはCompactDry™ 専用の顧客向けアプリケーションになります。
* スマートフォンアプリを利用の際にはWi-Fi環境下でのご利用を推奨いたします。
* 対象となる画像によっては、3%程度のカウント誤差が発生する場合があります。
* コロニーカウント結果が「0個」となった場合でも、結果が「陰性」を表すものではありません。
* 本サービスで使用しているクラウド画像認識技術は、島津ダイアグノスティクス株式会社と株式会社
日立ソリューションズが共同で開発した画像認識システム用のAI技術を使用しております。
* 本サービスの解析結果に関して、弊社では何ら責任を負うものではありません。
【@BactLAB 商標一覧について】
・CompactDry™および@BactLAB™は、島津ダイアグノスティクス株式会社の商標、または登録商標です。
・Google、Google Play、Androidおよびその他マークは、Google Inc.の商標です。
・Apple、Apple のロゴは、米国および他の国々で登録されたApple Inc.の商標です。App Store、AppleCare、iCloudは、Apple Inc.のサービスマークです。™ and ® Apple Inc. All rights reserved.
・AmazonおよびAmazon Web Serviceは、Amazon.com, Inc. またはその関連会社の商標、または登録商標です。
・Wi-Fi®は、Wi-Fi Alliance®の登録商標です。
・その他会社名、各製品名は、一般に各社の商標または登録商標です。
@BactLABでのグローバルクラウドを活用したデータ管理を行うことにより、食品製造に関連するサプライヤーや製造工場での品質管理が可能となります。今後はさらに、グループ企業における本社の品質管理部門(QC・QA統括部門)が、各拠点における原材料の受け入れ・加工・製造・生産・出荷・品質保証までの工程管理の状況を、リアルタイムに把握することが可能となるソリューション展開を推進することで海外市場における食品衛生の検査ビジネスを加速させる予定です。
【サービス・技術に関するお問い合わせ】
島津ダイアグノスティクス株式会社
海外営業部 eMail: contact@sdc.shimadzu.co.jp
デジタライゼーション部 eMail: bactlab-1@sdc.shimadzu.co.jp
〒110-8736 東京都台東区上野3-24-6 上野フロンティアタワー20F
https://corp.sdc.shimadzu.co.jp/english/
以上
このプレスリリースには、メディア関係者向けの情報があります
メディアユーザー登録を行うと、企業担当者の連絡先や、イベント・記者会見の情報など様々な特記情報を閲覧できます。※内容はプレスリリースにより異なります。
すべての画像
